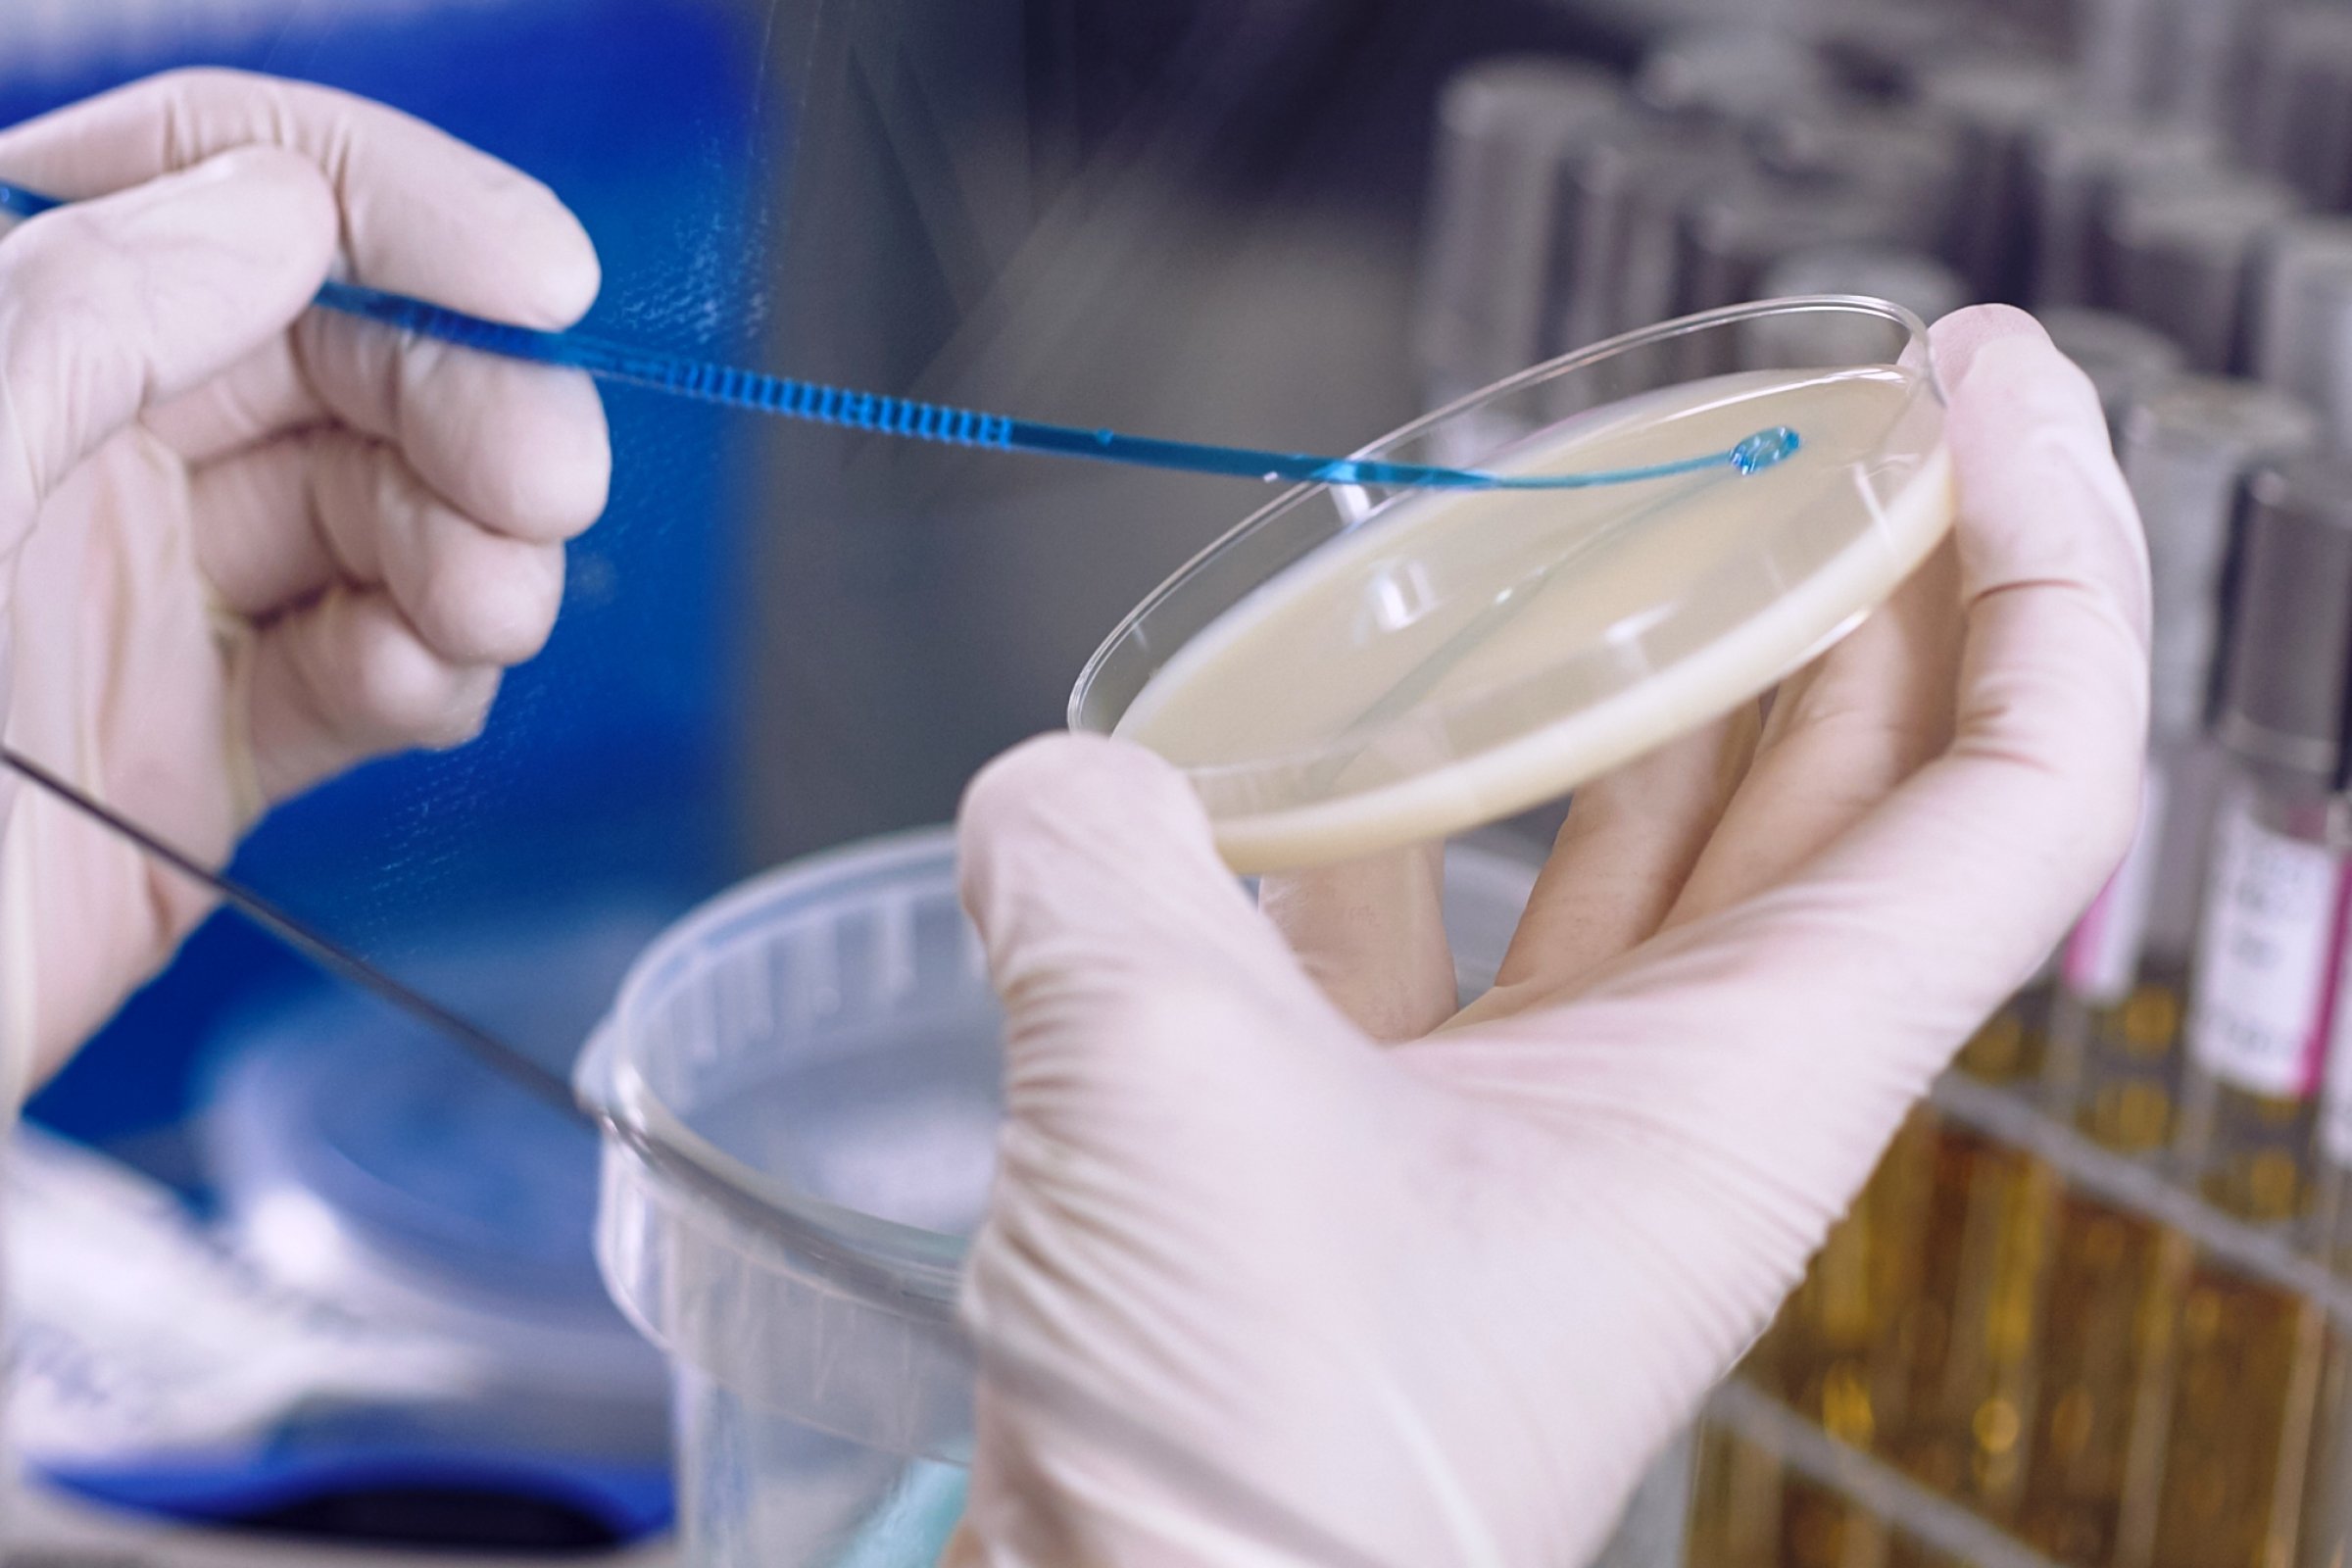

Bakteriologi
Bakterier er encellede mikroorganismer som finnes overalt på jorden og kan vokse i alle slags miljø. Noen bakterier kan forårsake sykdom hos dyr og mennesker.
Bakterielle infeksjonssykdommer klassifiseres i liste 1-, 2-, og 3-sykdommer. Liste 1-sykdom er svært alvorlige sykdommer hvor et utbrudd av en slik sykdom vil medføre store tiltak for bekjempelse. Liste 2-sykdom er alvorlige sykdommer som krever systematisk bekjempelse, mens liste 3-sykdom anses det som hensiktsmessig å holde en oversikt over av ulike årsaker.
Flere bakterielle infeksjonssykdommer regnes som zoonotiske, som betyr at de kan smitte mellom dyr og mennesker. Andre bakterier kan smitte dyr og mennesker via mat og fôr, eller via miljø.
Veterinærinstituttet har ansvaret for flere overvåkningsprogram på sykdom hos dyr forårsaket av bakterier på oppdrag fra Mattilsynet. Forekomst av antibiotikaresistente bakterier hos dyr og i dyrets miljø, samt i mat og fôr, overvåkes også.
Diagnostikk og forskning
Ved Veterinærinstituttet utføres både diagnostikk og forskning på liste 1-, 2- og 3- sykdommer, og insituttet har et særskilt beredskapsansvar på alvorlige dyre og fiskesykdommer, samt for utbrudd av matbårne sykdommer forårsaket av bakterier.
Diagnostikk av bakterier inkluderer identifisering, klassifisering og karakterisering av bakterier, og består av en rekke ulike klassiske mikrobiologiske metoder samt avanserte molekylærbiologiske metoder.
Veterinærinstituttet har flere BSL2 laboratorier, samt et avansert BSL3 laboratorium for forskning på bakterier og diagnostikk av bakterielle infeksjonssykdommer som det utgjør en risiko å arbeide med på laboratoriet.
Referanselaboratorium
Veterinærinstituttet er i Nasjonalt Referanselaboratorium (NRL) for flere bakterier i Norge.
Sykdom og agens
- Anaplasmose (sjodogg)
- Aviær klamydiose 2
- Aviær pasteurellose og hønsekolera 2
- Babesiose
- Bakteriell nyresyke (BKD) f
- Borreliose
- Brucellose 1
- Byllesjuke 3
- Campylobacter
- Digital dermatitt hos storfe
- Flavobacterium psychrophilum
- Fotråte hos sau 2
- Fotråte hos villrein
- Francisellose
- Furunkulose
- Kaldtvannsvibriose
- Kompleks gjellesykdom hos laks
- Kverke 2
- Leptospirose 2
- Listeria
- Lungebetennelse hos moskus
- Meticillinresistente stafylokokkar (MRSA) 2
- Miltbrann 1
- Mjøldrøye (Claviceps sp.)
- Mycoplasma bovis 2
- Mykobakteriose hos fisk
- Nekrobasillose
- Paratuberkulose 2
- Pasteurellose hos fisk
- Pasteurellose hos tamrein 3
- Piscirickettsiose
- Q-feber 2
- Raslesjuke
- Resistens mot bredspektrede cefalosporiner 3
- Resistens mot karbapenemer hos Enterobacterales 3
- Resistens mot kinoloner hos Enterobacterales
- Resistens mot kolistiner hos Enterobacterales 3
- Salmonella 2
- Shigella
- Smittsom øyebetennelse hos tamrein
- Staphylococcus aureus - matforgifting
- Tenacibaculose
- Tuberkulose 2
- Tularemi (harepest) 3
- Ulcerativ dermal nekrose (UDN)
- Verotoksinproduserande E. coli (VTEC/STEC)
- Vintersår
- Yersinia enterocolitica (yersiniose)
- Yersiniose hos fisk - Yersinia ruckeri
Prøvetaking og diagnostikk
Veterinærinstituttet utfører en rekke ulike typer diagnostiske undersøkelser for å oppklare og kartlegge sykdomsutbrudd og på oppdrag.
Rapporter
Forskningsprosjekt
- Yersiniose i sjøen
- WaterSafe
- Triploid laks – mottakelighet for smittsomme sykdommer
- Trampe
- Tenacibaculum spp. som en årsak til atypisk vintersår i norske oppdrettslaks
- TEiCON
- Smitte mellom oppdrettsfisk og villfisk: Kunnskapsstatus og risikovurdering
- PhageDrive
- Pasteurellose hos norsk laks
- Pan-genom analyse av Aeromonas salmonicida med fokus på genetiske determinanter for vertsspesifisitet
- OH4Surveillance
- Norwegian Airways
- NE kalkun - Nekrotiserande enteritt hos kalkun: Forebyggande tiltak, tidleg diagnostikk og ikkje-antibiotisk behandling
- MicroEndo
- Lever - pilot i Rogaland
- KLEB-GAP - Klebsiella pneumoniae, en sentral aktør i den globale spredningen av antibiotikaresistens og målbakterie for nyskapende diagnostikk, overvåkning og alternativ behandling
- Kan Enterococcus hirae være en ny årsak til spedgrisdiaré i Norge?
- IRA swine embryos - Importrisikovurdering av svineembryo
- INIKA_OH_TZ
- HUNT Én helse
- Hobbyhøns-prosjekt
- GizMo
- Flått i flokk
- Fisk for Utvikling i Ghana - Akvakultur
- EUPAHW - SPAMR-VET
- EU-WISH
- EU-JAMRAI - European Union Joint Action on Antimicrobial Resistance (AMR) and Healthcare-Associated Infections (HCAI)
- BactUlcer
- Aviærpatogene E. coli i norsk slaktekyllingproduksjon
Nyheter
- Årsrapport for Helseovervåkingsprogrammet for vilt (ViltHOP) 2021
- Yersiniose i norsk lakseoppdrett: kunnskapsstatus
- Villrein høsten 2020 – viktig kartlegging av fotråte
- Veterinærinstituttet tilstede på åpen dag hos AniCura
- Veterinærinstituttet representert på internasjonal konferanse innen antimikrobiell resistens
- Veterinærinstituttet med i nye nettverk innen antibiotikaresistens
- Veterinærinstituttet analyserer prøver på åpen dag hos AniCura dyreklinikk
- Veterinærinstituttet analyser matvareprøver for Salmonella Agbeni
- Utfordrende å vaksinere rognkjeks mot atypisk Aeromonas salmonicida
- Utbruddsetterforskning igangsatt etter at seks personer har fått E.coli-infeksjon
- Utbrudd av E. coli-infeksjoner (EHEC)
- Undersøker prøver for Listeria
- Stort steg for bekjempelse av yersinose
- Stor smittetrussel ved import av levende storfe
- Smittsom digital dermatitt (CODD) påvist i Sverige
- Slik testes hester og staller for Salmonella
- Sammen for bedre kyllingoverlevelse
- Salmonellasmitte kobles til kontakt med fugl, katt og miljøet rundt
- Salmonellainfeksjon hos katter
- Resistenstester alle prøver med sykdomsfremkallende bakterier
- Reptiler kan utgjøre en smittefare for mennesker
- Possibilities and challenges in the Ghana-Norway cooperation in aquaculture
- Oppdateringer om det nasjonale utbruddet av Salmonella Agona
- Nytt tilfelle av Salmonella Typhimurium påvist hos hest
- Nytt overvåkningsprogram på Mycoplasma Bovis - send inn prøver fra storfe gratis
- Nye tilfeller av fotråte hos sau i Rogaland
- Ny salmonellamistanke på hesteklinikken på NMBU
- Ny kunnskap om villfiskens gjellehelse
- Norsk storfe har lav forekomst av E. coli som kan gi alvorlig sykdom hos mennesker
- Norge tjener på å hindre antibiotikaresistens blant svin
- Mistanken om Q-feber er avkreftet
- Mistanke om utbrudd av salmonella
- Mistanke om Q-feber i norsk storfebesetning
- Mistanke om LA-MRSA i en svinebesetning i Nordland
- Miltbrann i Russland og Sverige
- Mange tilfeller av Salmonella hos katt tidlig på året
- Lite Shiga toksin-produserende E. coli i norske kjøttvarer viser ny kartlegging
- Listeria påvist i rakfisk
- Listeria påvist i rakfisk
- Klassisk vibriose hos villaks i Lysakerelva
- Jakter årsaken til syk laks i Enningdalselva (Berbyelva)
- Ingen funn av MRSA hos svin i 202
- Ingen funn av MRSA hos svin i 2018
- Import av hunder med ukjent opphav utgjør en smitterisiko
- Høst er tid for harepest som også kan smitte til menneske
- Hundesykdommen: Årsaken er fortsatt ikke funnet
- Helsemyndighetene etterforsker nasjonalt utbrudd av salmonella
- Harepest påvist i Trøndelag
- Gode resultater for MRSA-overvåkingen også i 2017
- Flere tilfeller av harepest i Sør-Norge
- Flere katter med Salmonella og utbrudd av småfuglsalmonellose
- Flere hester med mulig salmonellasmitte
- DNA-analyser bekrefter at Eksotisk miks var årsaken til salmonellautbrudd
- Disputas -risikofaktorer for antibiotikaresistens i norsk kylling
- Dette vet vi om Salmonella Typhimurium-bakterien
- Bioinformatisk prosedyre på plass for analyse av bakteriers arvestoff
- Bakteriell nyresyke hos oppdrettslaks i Midt-Norge
- Antibiotikaresistens hos rødrev kan knyttes til menneskelig aktivitet